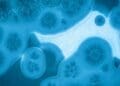
primate gut bacteria

Darwin may have doubted it at first, but modern science suggests otherwise. The planet and all its living organisms varied greatly from the ones we know today. Evolution ensured that these organisms, including ourselves, adapted to the evolving world around us, ensuring our survival. However, the evolution of eyes was misunderstood for quite some time. Now that our insights have improved, it seems our sight is evolving yet again. Will human eyes change for good?
Evolution: An inevitable event
The concept known as evolution is not just a past event, but is continuously shaping our present and our future. Imagining what unique features mankind may have thousands of years from now is thrilling, even creating a sense of wonderment.
Perhaps this is how Charles Darwin felt when he hypothesized the theory of evolution and natural selection? While we may never truly know, there is one organ that proved to be a dilemma to Darwin. He published The Origin of Species in 1859, and in this book, he noted that it seemed absurd to credit the creation of the eye to natural selection, which he believed was the main driver of evolution.
However, Darwin still deemed the gradual evolution of eyes plausible. His reason behind? As long as a small change in eyes led to a survival advantage, regardless of how slight the advantage may be, then natural selection most likely drove the evolution of eyes. Modern science has provided more detailed proof that eyes have evolved, and suggests that human eye evolution is still occurring.
Human eyes: The insight behind our eyesight
Evolution occurs in varying ways, from the gradual evolution of oil production in the U.S. to microscopic DNA segments in the eye evolving to adapt eyesight. However, the latter example took much longer than the first. Carl Zimmer, a science and environment lecturer at Yale University, provided insight into opsins and their historical evolution that shaped modern eyesight.
Opsins are molecules that capture light and transmit electrical messages via photoreceptors to the brain. There are two types, namely c-opsins, typically found in vertebrate bilaterians (mammals, fish, reptiles, etc.), and r-opsins, typically found in protostome bilaterians (insects, snails, worms, spiders, etc.). However, in recent years, it has been discovered that vertebrates, such as humans, also have r-opsins that process captured images.
Likewise, c-opsins were discovered in ragworms, suggesting that bilaterians shared a common ancestor that had both opsins. Millions of years of evolution and divergence led to the creation of the modern human eye, and if history and science have taught us one thing, it is far from over.
The next step in evolution: A different outlook
All living organisms had to adapt to their ever-changing environments, including humans and their eyes. At some point during evolution, vertebrate ancestors had light-sensitive eyespots on their brains abundant with photoreceptors and c-opsins. These eyespots eventually “ballooned” to the side of the head and folded inwards.
Now it seems our eyes are evolving again due to the impact of the Digital Age, where AI, computing, and the internet have consumed our daily lives. We are becoming more susceptible to developing myopia (nearsightedness), as we have adapted to working in environments with crowded visual spaces, non-natural lighting, near work, and altered diets.
Experts predict that myopia rates will reach 50% by 2050, due to the multifactorial conditions that have caused our eyes to become more elongated as a “survival adaptation.” However, it is not ideal, and caregivers are working hard to halt and/or prevent it. Life without digital technologies is unimaginable, as these technologies help lower emissions in oil and gas, among others, but perhaps mimicking past environments is the only way to stop this evolution.